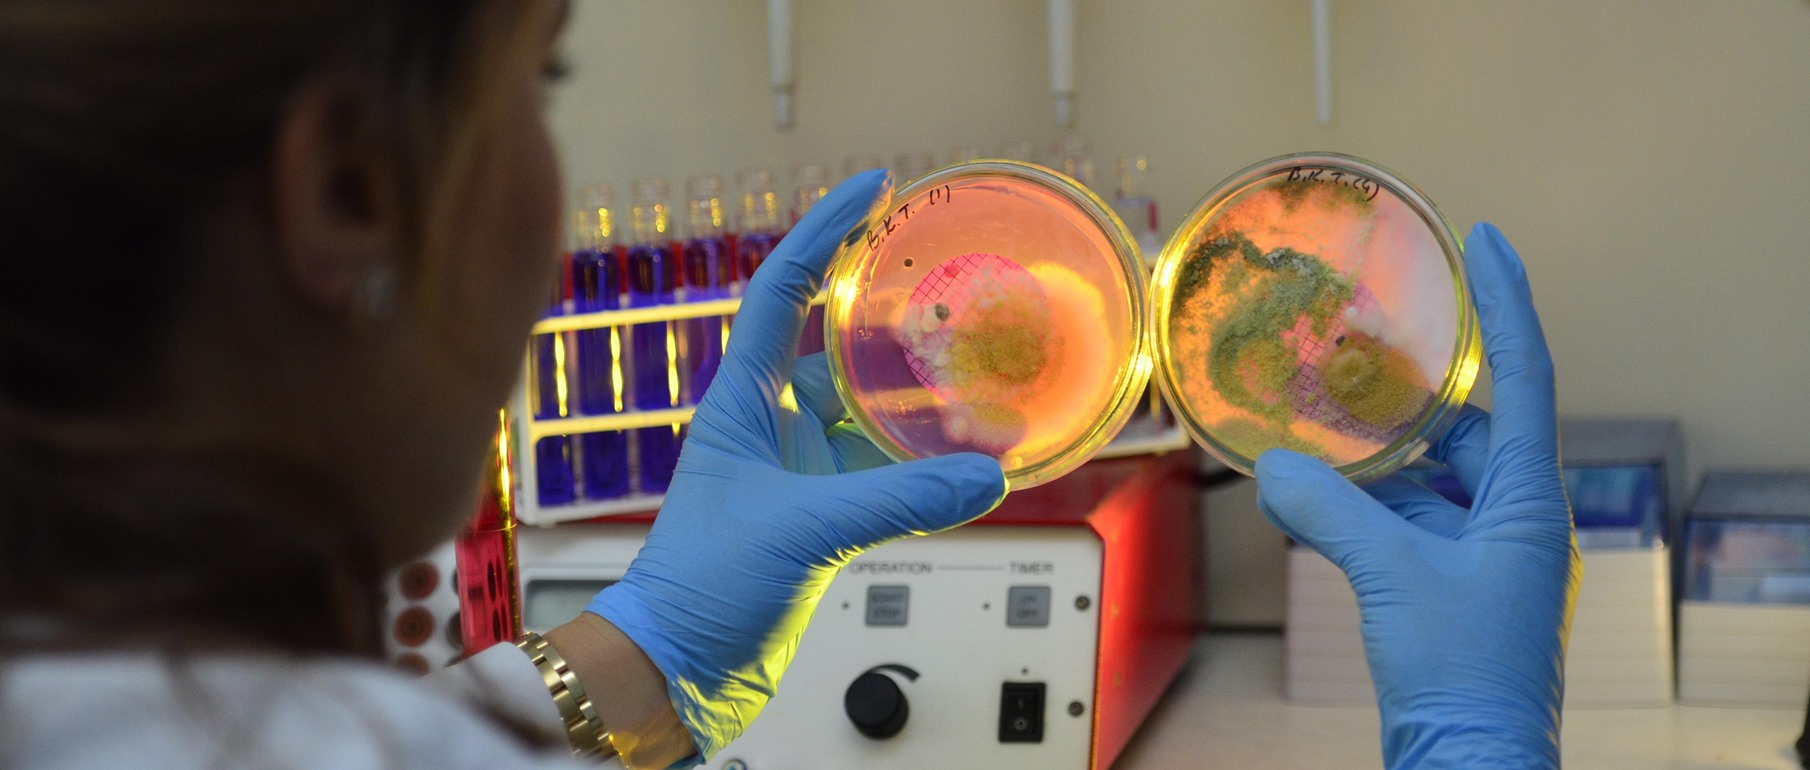

researchgate

www aa com tr

2

eskisehir osmangazi universitesi

docplayer

unedex

yumpu

genel bilgiler eskisehir osmangazi universitesi

eskisehir osmangazi universitesi obs ogu ogrenci giris yks universite

www ogu edu tr

eskisehir osmangazi universitesi

huzur sayfasi

esogu enformatik bolumu eskisehir osmangazi universitesi

eskisehir osmangazi universitesi

udef uluslararasi ogrenci dernekleri federasyonu

www ogu edu tr

duyurular eskisehir osmangazi universitesi

esogu yeni ogrenci kayit islemleri eskisehir osmangazi universitesi

facebook

haberler eskisehir osmangazi universitesi

slideplayer

twitter

www ogu edu tr

facebook

vektorel cizim eskisehir osmangazi universitesi sitesini yeniledi

ogrenci kariyeri

eskisehir anadolu universitesi
www ogu edu tr

bilgi islem daire baskanligi eskisehir osmangazi universitesi

apkpure com
You May Like

